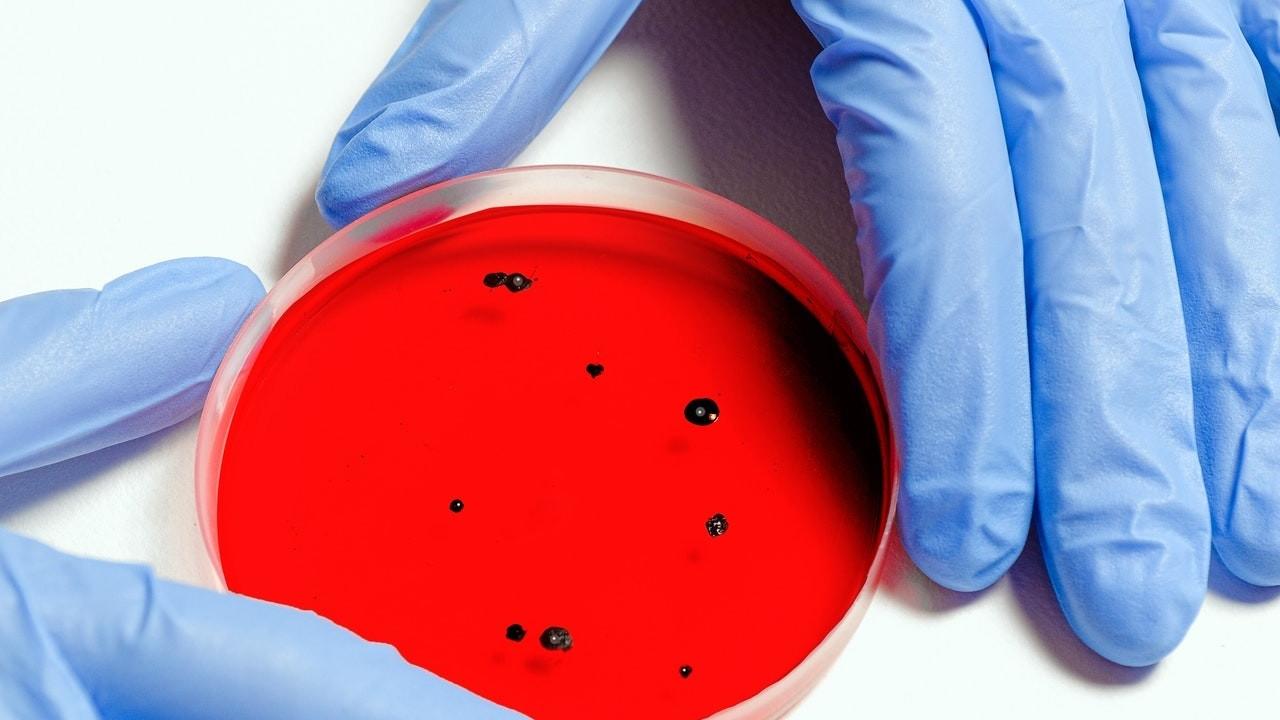

The best time to go for a stroll
Oct 22, 2020
Fast walk your way to better brain function
May 16, 2020
What is a Virus?
Mar 30, 2020
Milk…good or bad, full fat or low fat?
Feb 25, 2020